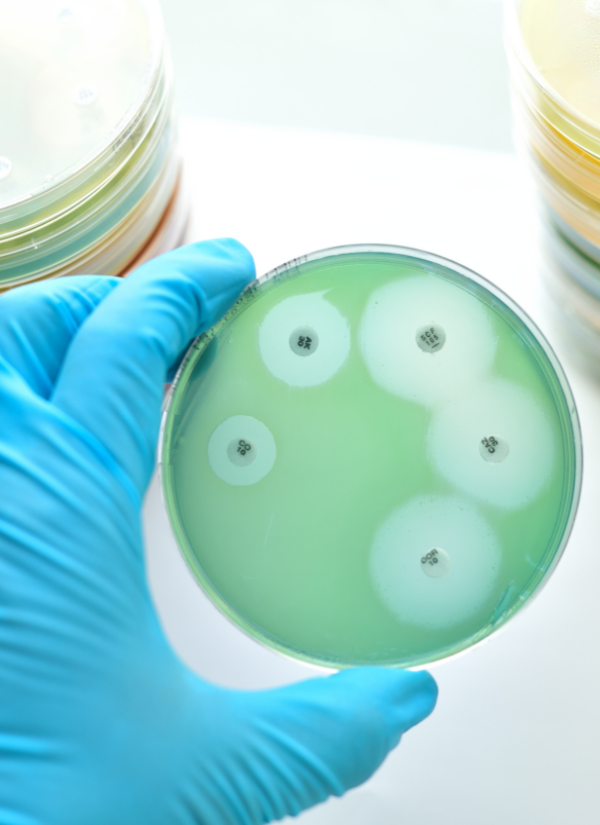

For nearly four decades, Kelly has been a cornerstone of Dynacare’s Microbiology department. With 39.5 years at the organization and 42 years as a Medical Laboratory Technologist (MLT), she brings a depth of knowledge and leadership that anchors her team and supports patient care across Manitoba.
As Charge Technologist, Kelly is responsible for the release of all patient results generated in the microbiology lab. Her workday is a balance of hands-on bench testing – her top priority – and the behind-the-scenes tasks that keep the department running smoothly: responding to emails, ordering supplies, problem-solving, and managing inventory.
Kelly’s work plays a critical role in guiding patient treatment.
“All testing in microbiology helps the physician decide which specific antibiotic to use,” she says. “Physicians may have an idea of how to treat an infection, but it’s the lab’s confirmation that ensures patients get the most effective medication.”
Kelly’s path into health care started in high school, when she enrolled in a microbiology elective without knowing much about it. She had initially planned on becoming a veterinarian, however the lack of a local training program combined with her teacher’s passion for microbiology ultimately shaped her career.
After training as a biological technologist and general medical technologist, Kelly briefly worked in hematology and chemistry before taking up a position in microbiology. Now, as Charge Technologist, she feels she has reached the goals she set for herself early in her career.
No two days are the same.
What she enjoys most about her job is that no two days are the same.
“There really isn’t anything routine in microbiology,” she says. “Every day is a new learning experience and challenge, which I really enjoy!”
Technology remains one of her biggest challenges, especially having started her career before computers were part of laboratory work. Kelly says her team has been an invaluable resource when she runs into technology issues.
“I am very fortunate to have many other colleagues skilled in computer systems and programs who I can rely on.”
To Kelly, success in the lab is a team effort. Whether it’s the Laboratory and Health Services Centres (LHSC), drivers, warehouse staff, technologists, or technicians, she sees every day as a collective success story.
“They all band together to create a huge success story every day!”
Systemic challenges for health care
When she looks at Manitoba’s health-care system, she worries most about long waits in emergency rooms and for surgical procedures – challenges she believes stem from chronic understaffing. If she could change one thing, she would restore the hospital operations that existed before emergency departments were removed.
“Sure, they saved money, but patient care has been greatly affected.”
Her message to anyone considering a career as an MLT is simple: it’s rewarding, vital work that often goes unseen.
“Most people outside the lab community do not even realize that we exist or that doctors do not do the actual testing. We are the behind-the-scenes hard-working group of people!”
Outside of work, Kelly enjoys spending time with her family and friends most of all, and stays active by playing with and training her puppy. Although she has retired from curling, she loves to watch her son and brother-in-law curl during the busy season of bonspiels!